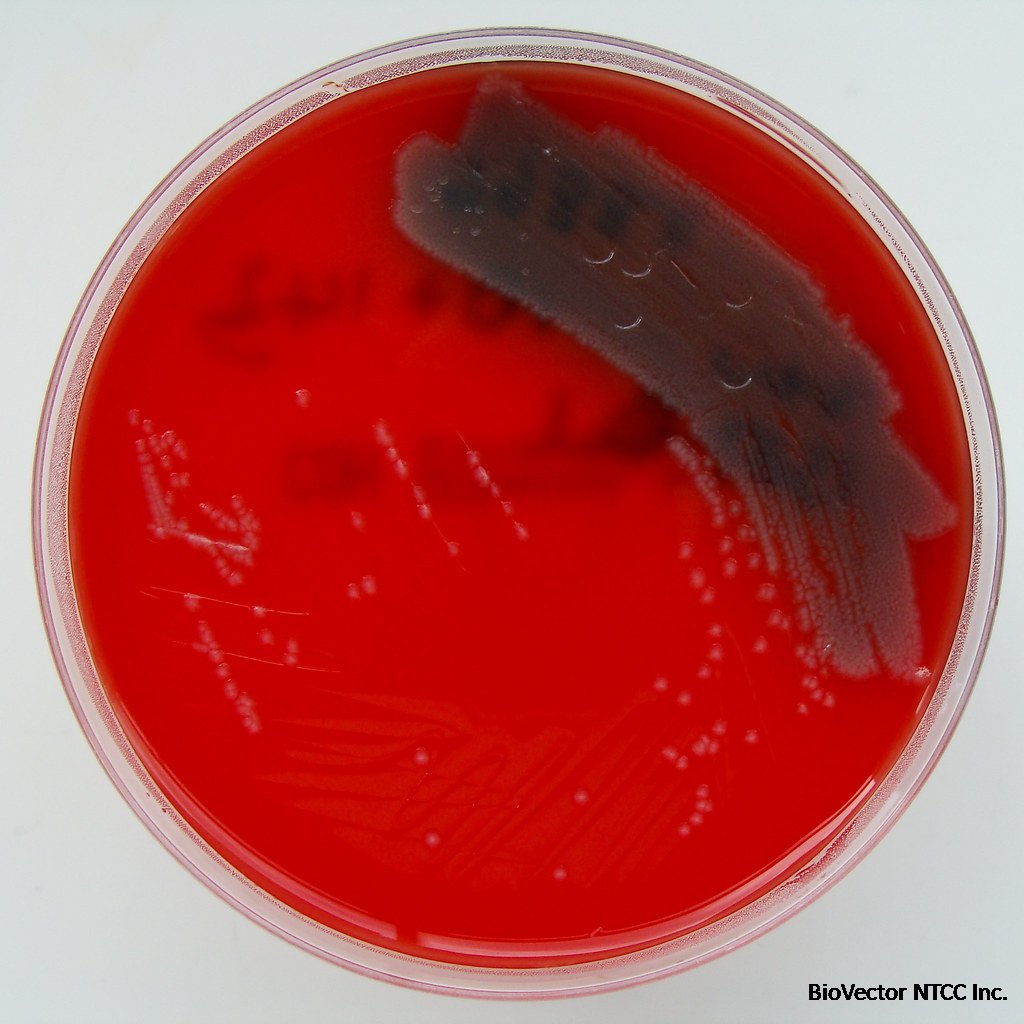
Pseudomonas aeruginosa on Columbia Blood Agar | Pseudomonas … | Flickr

Pseudomonas aeruginosa NCTC 10662 NTCC®铜绿假单胞菌-BioVector NTCC Inc.
- 价 格:¥49850
- 货 号:NTCC®Pseudomonas aeruginosa NCTC 10662
- 产 地:北京
- BioVector NTCC典型培养物保藏中心
- 联系人:Dr.Xu, Biovector NTCC Inc.
电话:400-800-2947 工作微信:1843439339 (QQ同号)
邮件:Biovector@163.com
手机:18901268599
地址:北京
- 已注册
Pseudomonas aeruginosa NCTC 10662 NTCC®铜绿假单胞菌-BioVector NTCC Inc.
Pseudomonas aeruginosa NCTC 10662 is a specific strain of the bacterium Pseudomonas aeruginosa. It is commonly used in scientific research and quality control.
K
ey Characteristics:
Strain Origin: NCTC stands for the National Collection of Type Cultures, a UK-based organization that maintains a collection of microorganisms.
Reference Strain: This strain is often used as a reference standard in microbiological testing.
Quality Control: It is commonly used to assess the accuracy and reliability of laboratory methods and techniques.
Research Applications: It may also be used in research studies on Pseudomonas aeruginosa, such as investigating its virulence factors, antibiotic resistance, and biofilm formation.
Applications:
Method Validation: Used to verify the accuracy and precision of microbiological methods.
Strain Identification: Used to compare and identify other strains of Pseudomonas aeruginosa.
Antibiotic Susceptibility Testing: Used to evaluate the effectiveness of antibiotics against the bacterium.
Biofilm Studies: Used to investigate the formation and properties of biofilms, which are complex communities of bacteria.
Safety Considerations:
Pseudomonas aeruginosa is an opportunistic pathogen that can cause infections in humans.
It is important to handle this strain with appropriate safety precautions in a laboratory setting.
This includes using sterile techniques and personal protective equipment.

生产厂家Supplier:
BioVector NTCC质粒载体菌株细胞蛋白抗体基因保藏中心
E-mail:BioVector@163.com
- 公告/新闻




